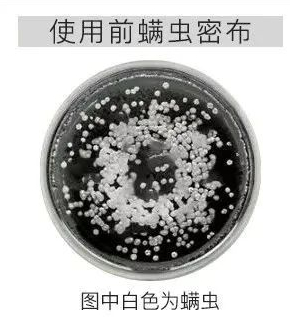

原标题:5天不洗头也不油?!搞定这件事,头发蓬松又清爽!
拥有蓬松、清爽的头发,可以让男人看起来更阳光,女人挡不住的明媚动人。
不得不承认,一头蓬松又柔亮的头发,真的能瞬间提升一个人的气质。
但是现实生活却是这样的:前一天才洗完的头,第二天头发就变得又油又塌,不仅显邋遢更显得脸大。

头发油腻、扁塌,你看到的只是表面,头发容易油其实是头皮发出的警告!
头皮上堆满油脂、头皮屑、分泌物,不仅会让头发更有“重量感”,扁塌粘在一起,而且油腻的环境还会变成有害微生物的“欢乐场”,导致头皮出现头痒、头皮屑等诸多问题。

所以在平时洗发的同时,不仅要调整头皮油脂分泌,减轻发丝负担,让头发更加轻盈有空气感。
更重要的是,就像清理我们皮肤的黑头堵塞一样,定期清理头皮堵塞,让头皮能够“畅快呼吸”!
今天就给大带来一款专为头皮问题研制的——盐致头皮舒缓洗发膏,可以1瓶同时搞定清洁+洗发。

注:不会操作微信购物的读者,可拉至本文底部,添加客服微信好友,联系客服帮您下单。
【微信专享福利】
购买1盒
送身体磨砂膏旅行装
购买2盒
送沐足球
还等什么
点击下方进行购买
了解商品详情
▼
这款海盐洗发膏对于头发容易出油、扁塌的宝宝来说,简直是打开了新世界的大门!
平时2天不洗,头发油得发丝能粘在一起的大油头,洗完之后,头发立马变蓬松。
这款深层洁净头皮的磨砂膏,虽然质地更偏向于泥状,但仍然可以感受到海盐的颗粒感。

这种海盐颗粒能够有效清洁头皮表层的多余污垢和油脂,使用起来也跟洗发水差别不大,打湿头发后,挖出一点洗头膏在头发上揉搓,膏体就能很快溶解,搓出非常非常多细腻的泡沫。

所以它也很适合懒人哦,根本不需要额外再用洗发水,一瓶搞定头皮清洁+洗发。

洗发头发就很蓬松,不会“软趴趴”地塌在头皮上。甩一下头发,感觉跟电视里的洗发水广告一样
洗完头皮特别舒服,感觉轻松了很多,头皮像被吸尘器吸过一样清爽。

天然生态海盐
温和清洁,头皮、毛囊的“吸尘器”

这款洗发水中的核心成分,是来自北纬20°的纯净天然生态海盐。具有很强的清洁、控油能力,是兼具温和与有效清洁与一体的天然成分。

生态海盐非常细的盐粒能随着按摩慢慢溶解,深入头皮底层,疏通头皮,轻松带走油脂等杂质。

抑制头皮过度分泌油脂,并且让头皮环境更加健康,这样即便是三天不洗头,头发也不会油得很厉害了!

而且长期使用下来,头发会特别蓬松,不会紧紧贴在头皮上,有非常自然的空气感。
生态海盐作为细密的晶体颗粒,具有温和去角质的效果。它可以帮助头皮死皮、角质顺利脱落,能够从根本上解决油腻问题。

这款洗发膏中的生态海盐来自中国“无污染”·稀缺生态海盐田——雷州半岛盐场。

这里的海水干净纯澈,每年仅产5万吨生态海盐,重要的是其中富含非常多的活性矿物质和微量元素。

不仅如此,生态海盐液还可以除螨!
显微镜镜头下进行对比,在实验器皿中培育大量螨虫,然后滴入生态海盐解液,3分钟之后螨虫基本全消失了!
所以洗完之后整个头都觉得松快了,天然生态海盐成分更是带来一种自然的柔顺蓬松和自信!
注:不会操作微信购物的读者,可拉至本文底部,添加客服微信好友,联系客服帮您下单。
【微信专享福利】
购买1盒
送身体磨砂膏旅行装
购买2盒
送沐足球
还等什么
点击下方进行购买
了解商品详情
▼
▼

草本配方
生态海盐+6重石斛精华
这款盐致海盐膏采用了广州中医药大学工程研究院研制的草本配方,从整整6种珍贵石斛中提取出营养液,全面滋养修护受损头皮。

其中比较知名的就是铁皮石斛了,自古以来,铁皮石斛又被誉为“千金草”,具有非常高的价值。

广州中医药大学研究人员结合其他六种珍贵的石斛提取物,使这款头皮磨砂膏,具备了强大的滋养修护的能力。

这些珍贵的石斛成分能够促进毛囊修复,恢复头皮层的细胞活性,洗完头之后蓬松不油还不会太干!

清洗一段时间后,你会发现,头发不怎么油了、清爽又舒畅!

改善毛糙分叉
头发顺起来了
这款洗发膏还能滋养你受损的头发,它添加了三七精萃,还有多糖氨基酸精华来帮助头发生长。

三七精萃能有效滋养秀发,修护一扯就断的受损发丝;
氨基酸为头发提供足够的营养,还能深层补水让头发柔顺自然,水润有光泽。

从本质上拯救你已经受损的头皮,头皮疏通健康了,就能告别大油头。

这款海盐洗发膏还拥有强大的品牌背景和研发实力。
广东省盐业集团,成立于1956年,也是拥有70年历史的国营企业,而且已经连续生产经营70年了!


不仅如此,本款系列产品还都是经过广州中医药大学研究院的研发团队培育开发,在头皮养护上拥有强大的技术、理论支撑,更值得信赖。


这款海盐洗发膏还真正做到了温和天然,不含硅油、酒精、荧光剂、人工色素、防腐剂等有害物质,无添加的温和配方,就连孕妇、小孩也可以放心使用哦!
头发问题不要愁,这个夏天,你的头发,就由海盐洗发膏来守护~
现在购买,还有惊喜福利哦!下单1盒送身体磨砂膏,2盒送沐足球,还等什么呢,赶快抢购吧!

注:不会操作微信购物的读者,可拉至本文底部,添加客服微信好友,联系客服帮您下单。
【微信专享福利】
购买1盒
送身体磨砂膏旅行装
购买2盒
送沐足球
还等什么
点击下方进行购买
了解商品详情
▼
▼
————————
想享受更多产品折扣与优惠活动吗?
一切尽在微信朋友圈
添加客服微信
随时随地享受产品特价
大把折扣等你来
部分特价产品一览
点击下方图片了解商品
↓↓↓
联系客服
长按下方图片
添加客服微信好友
↓↓↓